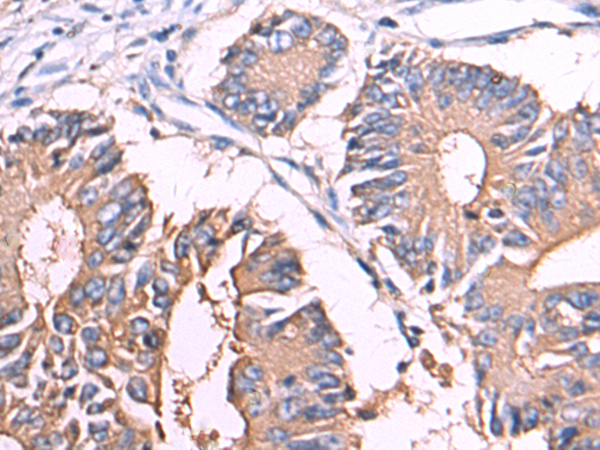
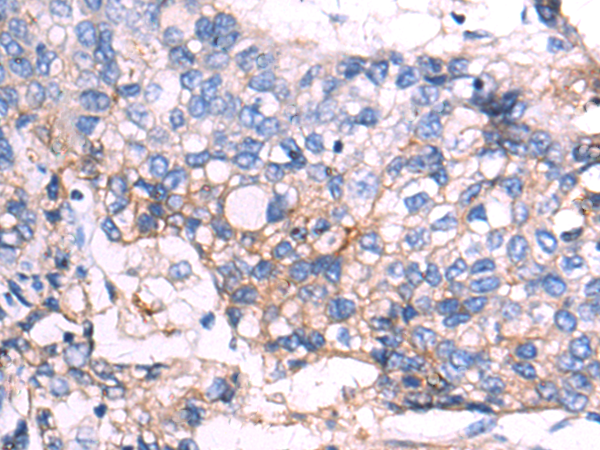

-
分类: 科研抗体货号: P00261别名: CD67; CGM6; CD66b; NCA-95应用: IHC反应种属: Human
-
分类: 科研抗体货号: P00330别名: SK; DKK-1应用: WB,IHC反应种属: Human, Mouse
-
分类: 科研抗体货号: P00303别名: HSS; CMDR; CX43; EKVP; GJAL; ODDD; AVSD3; HLHS1; PPKCA应用: WB反应种属: Human, Mouse, Rat
-
分类: 科研抗体货号: P00320别名: LAMPB; CD107b; LAMP-2; LGP110应用: WB,IHC反应种属: Human
-
分类: 科研抗体货号: P00334别名: DKK-2应用: IHC反应种属: Human, Mouse
-
分类: 科研抗体货号: P00300别名: CUL-3; PHA2E应用: WB,IHC反应种属: Human, Mouse, Rat
-
分类: 科研抗体货号: P00319别名: CSCD; PG40; PGII; PGS2; DSPG2; SLRR1B应用: WB,IHC反应种属: Human, Mouse, Rat
-
分类: 科研抗体货号: P00333别名: DKK-4应用: IHC反应种属: Human
-
分类: 科研抗体货号: P00362别名: MKP5; MKP-5应用: WB,IHC反应种属: Human, Mouse
-
分类: 科研抗体货号: P00317别名: NY-CO-3; SDCCAG3应用: WB,IHC反应种属: Human, Mouse

鄂公网安备42018502007531号
鄂公网安备42018502007531号

